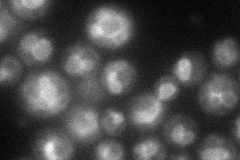
YIL088C
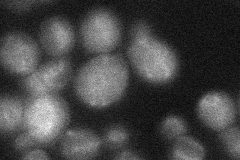
YIL088C

View description
Putative transporter, member of a family of seven S. cerevisiae genes (AVT1-7) related to vesicular GABA-glycine transporters
Localization:
Intensity:
Fold change:
Significance:
-
C’ GFP library in SD

ER18.64 -
N' NOP1pr-GFP in SD
vacuole membrane65.2649 -
N' TEF2pr-mCherry in SD

vacuole membrane91.6231 -
N' NATIVEpr-GFP in SD
vacuole membrane22.0029 -
N' TEF2pr-VC and Cyto-VN in SD

below threshold27.8518 -
C’ GFP library in SD+DTT

ER15.150.81No -
C’ GFP library in SD+H2O2

ER16.440.88No -
C’ GFP library in Starvation Media

ER18.080.96No -
C’ GFP library on the background of Pup2-DaMP

ER -
C’ GFP library on the background of CCT mutant

ER16.62230.891203No
